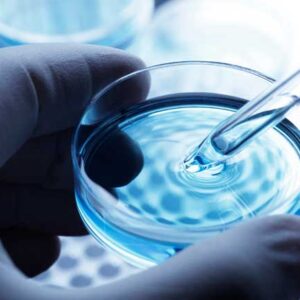
DISPOSITIVOS MÉDICOS

-
AEROESPACIAL E INDUSTRIAL (88)
En la industria aeroespacial, cada componente y proceso debe cumplir con los más altos estándares de calidad, seguridad y precisión. Desde la fabricación de piezas críticas hasta el mantenimiento de entornos controlados, el éxito depende de herramientas, materiales y equipos que ofrezcan un desempeño confiable y consistente. En DTB, entendemos las necesidades únicas del sector aeroespacial industrial. Ofrecemos soluciones especializadas… -
CUMPLIMIENTO USP 797 (179)
El cumplimiento de las normativas USP 797 es esencial para garantizar la seguridad, calidad y esterilidad en la preparación y administración de medicamentos en entornos farmacéuticos y de salud. En DTB, ofrecemos una amplia gama de productos para cumplimiento USP 797 diseñados para ayudar a las instalaciones de salud, farmacias y laboratorios a mantener estándares óptimos en la preparación de… -
DISPOSITIVOS MÉDICOS (175)
Los productos para la producción de dispositivos médicos son esenciales para garantizar la calidad, seguridad y eficacia en el desarrollo de equipos médicos modernos. Estos dispositivos, que van desde equipos de diagnóstico hasta herramientas quirúrgicas, dependen de componentes y soluciones de alta precisión para cumplir con los estándares regulatorios y ofrecer un rendimiento óptimo en procedimientos médicos críticos. En DTB… -
ELECTRÓNICA (112)
Productos para la Industria Electrónica En la industria electrónica, la precisión y el control de contaminación son fundamentales para garantizar la calidad y el rendimiento de los productos finales. Nuestros productos para la industria electrónica están diseñados para ofrecer soluciones de limpieza, protección y mantenimiento, cumpliendo con los más altos estándares de la industria. Desde cuartos limpios especializados hasta equipos… -
EPIDEMIAS Y CONTINGENCIAS (149)
En situaciones de epidemias y contingencias, contar con productos especializados es fundamental para proteger la salud y garantizar la seguridad en diversos entornos. Nuestra categoría de Epidemias y Contingencias ofrece soluciones diseñadas para reducir riesgos de transmisión, asegurar la limpieza y desinfección efectiva, y proteger tanto a las personas como a los espacios en momentos críticos. Aquí encontrará una amplia… -
FARMACÉUTICA (179)
En DTB, contamos con más de 25 años de experiencia y una amplia gama de productos y servicios especializados para la industria farmacéutica. Sabemos que mantener un ambiente controlado y altamente regulado es esencial para garantizar la calidad, seguridad y eficiencia en la producción de medicamentos y productos farmacéuticos. Ofrecemos soluciones avanzadas en control de microcontaminación, desinfección, limpieza, protección para… -
HEMODIÁLISIS (101)
Los productos DTB para hemodiálisis están diseñados para optimizar el funcionamiento de las clínicas, mejorando la eficiencia operativa sin comprometer la seguridad del paciente. Entre nuestras soluciones más destacadas se encuentran los dializadores CLEARFEX® y el Sistema de Reproceso del Dializador Renatron® II, herramientas esenciales para el manejo rentable y seguro de los tratamientos de hemodiálisis. El Sistema de Reproceso… -
HOSPITALES (165)
Las salas blancas y cuartos limpios en hospitales son espacios críticos donde el control de la contaminación es esencial para proteger la salud de los pacientes y del personal médico. Contar con soluciones especializadas para el mantenimiento y operación segura de estos espacios es fundamental para garantizar su correcto funcionamiento y cumplir con las regulaciones de calidad en el entorno…